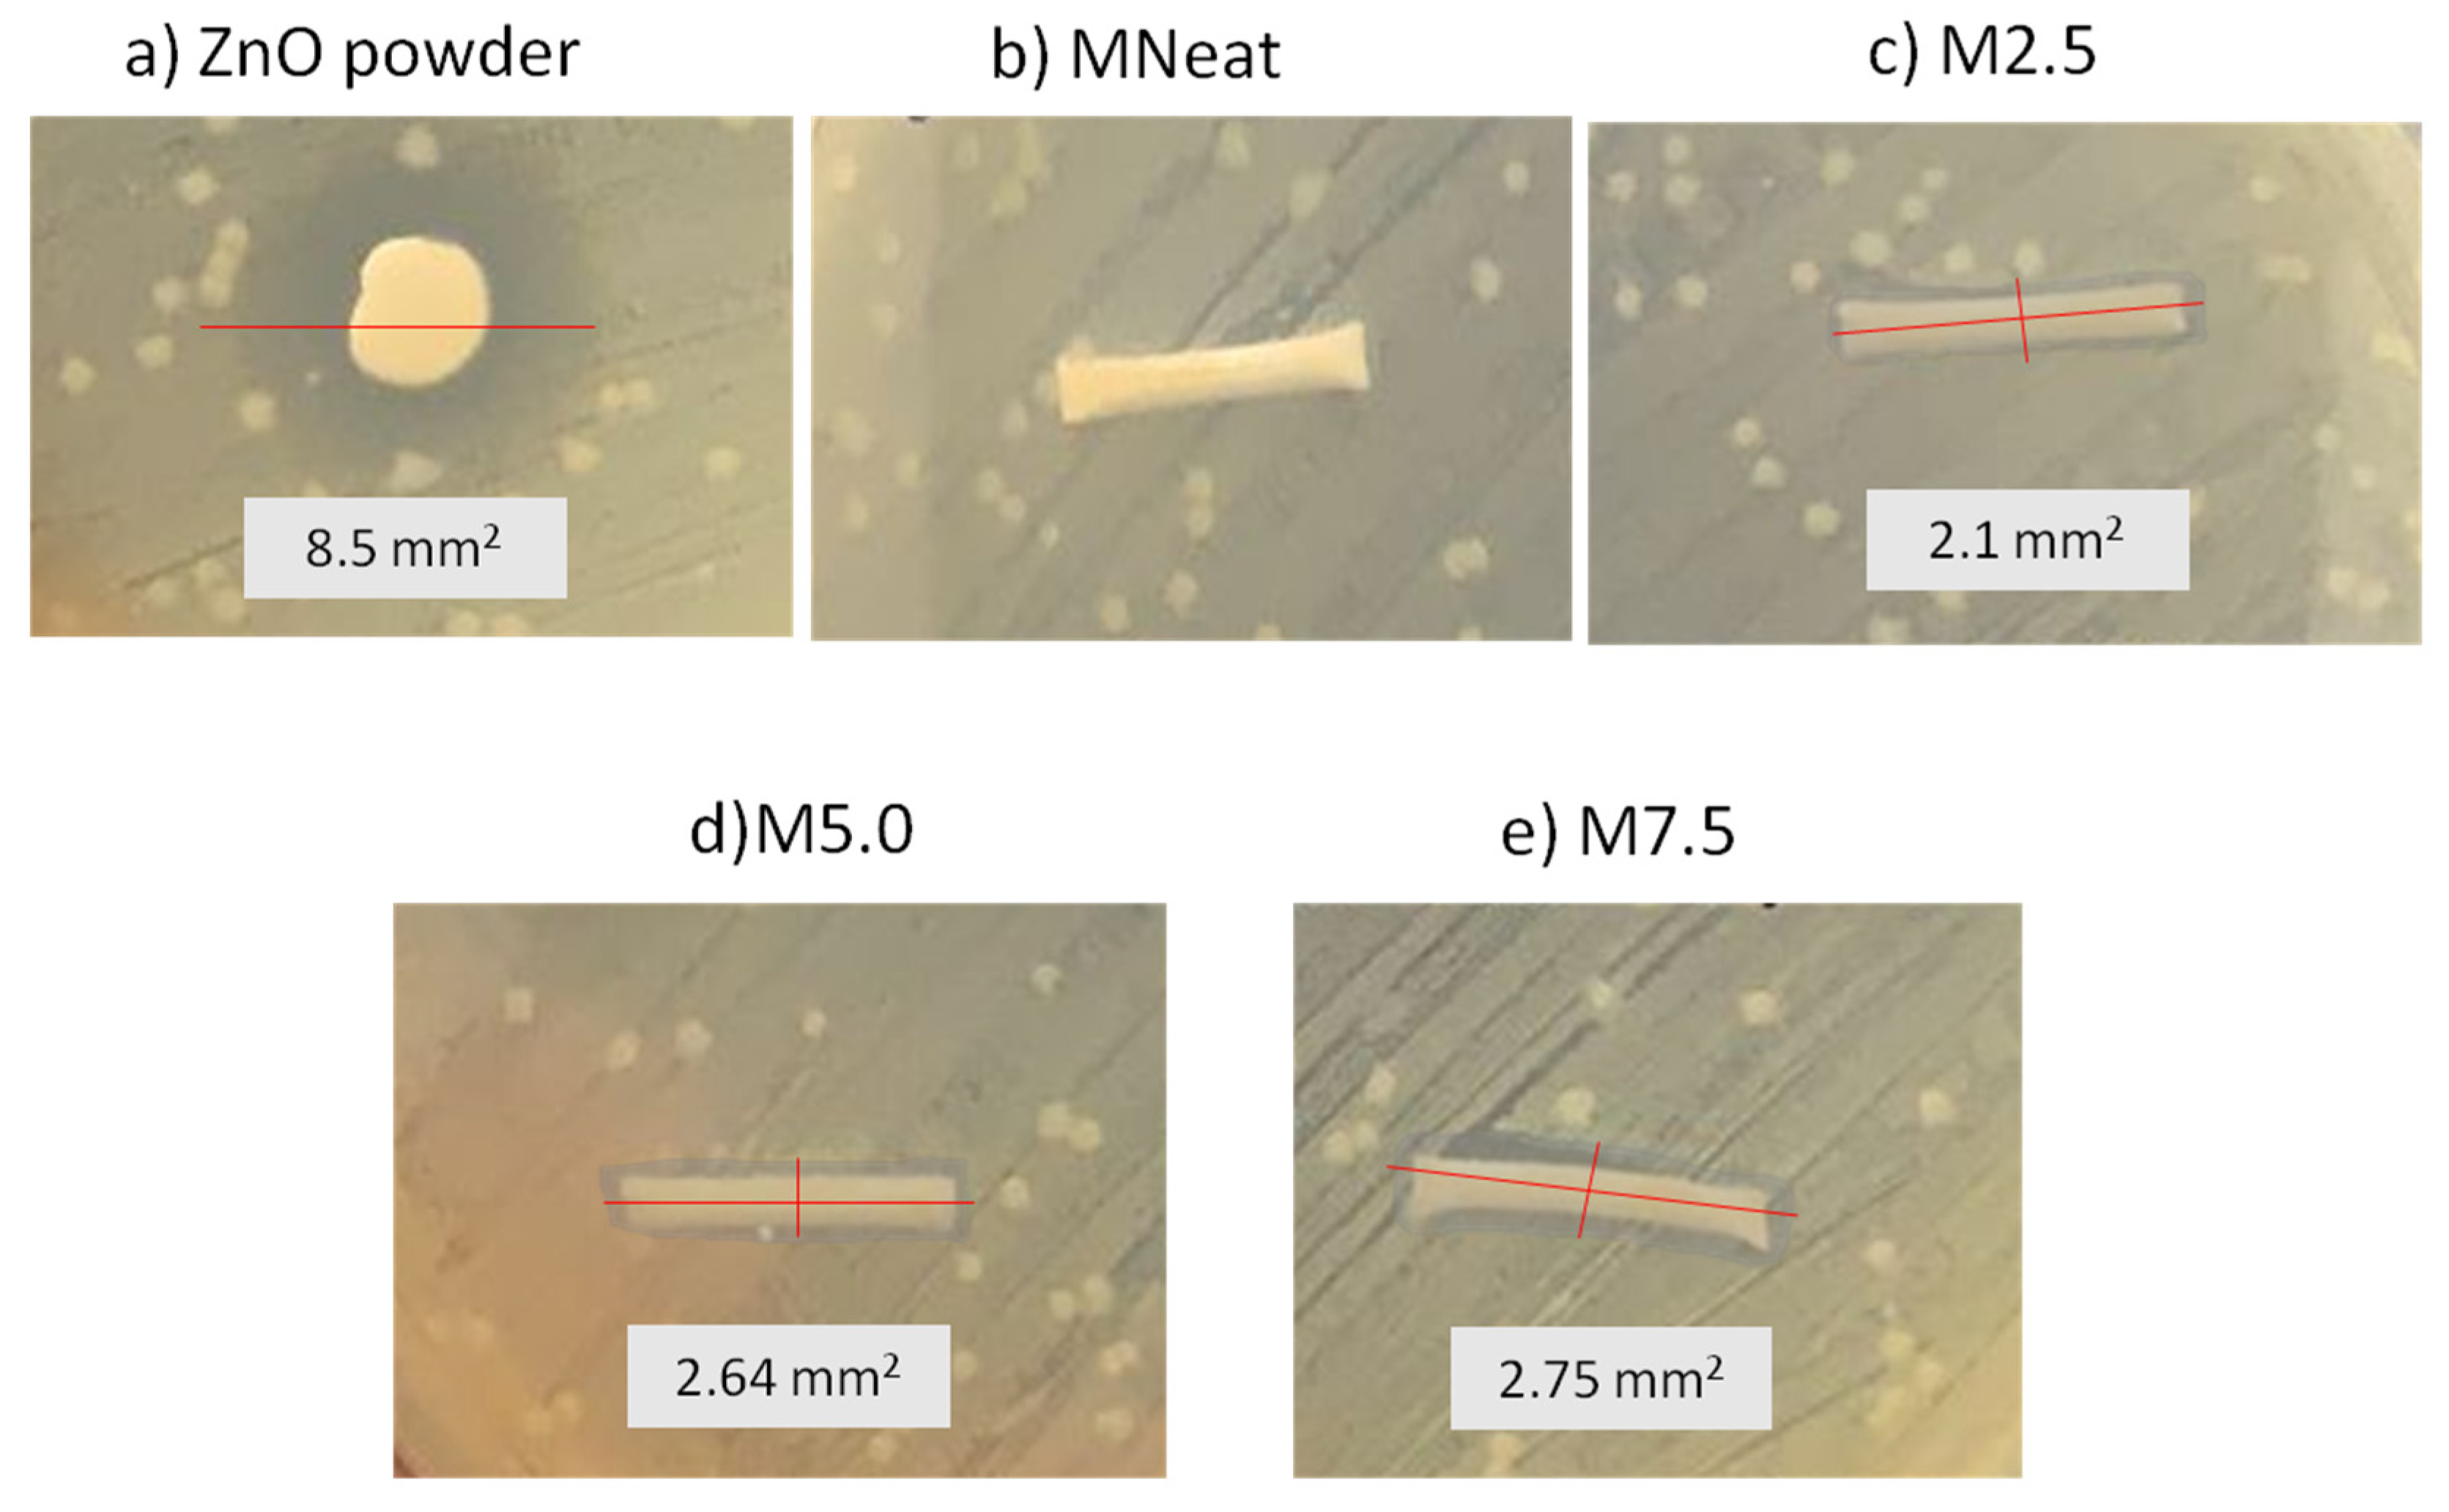
Membranes 12 00110 g006 Membranes 12 00110 g006

Polyvinylidene Difluoride (PVDF) Hollow Fiber Membrane Incorporated with Antibacterial and Anti-Fouling by Zinc Oxide for Water and Wastewater Treatment
Abstract
1. Introduction
2. Materials and Methods
2.1. Membrane Material
2.2. Fabrication of ZnO/PVDF Antibacterial Hollow Fiber Membrane (AHFM)
2.3. Characterization Study of ZnO/PVDF Antibacterial Hollow Fiber Membrane (AHFM)
2.3.1. Morphological Analysis
2.3.2. Contact Angle
2.3.3. Porosity and Pore Size
2.3.4. Fourier Transform Infra-Red (FTIR) Spectroscopy
2.4. Antibacterial Properties Testing ZnO/PVDFAHFM
2.5. Membrane Performance: Pure Water Flux, BSA Rejection and Antifouling of ZnO/PVDF Antibacterial Hollow Fiber Membrane (AHFM)
- F = membrane flux (L/m2 h)
- V = volume of permeate at time (t)
- A = effective filtration area of the membrane (m2),
- do = outer diameter of hollow fibers (cm)
- L = effective length of hollow fibers (cm).
- C0 = initial concentration of feed solution
- C1 = concentration value of the permeate solution.
- Jw1 = pure water flux
- Jw2 = pure water flux of the cleaned membrane.
3. Results
3.1. Physical Properties
3.2. Chemical Properties
3.3. Antibacterial Activity of ZnO/PVDF AHFM
3.4. Flux Performance and Rejection Capability
3.5. Antifouling Performance
4. Conclusions
Author Contributions
Funding
Data Availability Statement
Conflicts of Interest
References
- Doran, P.M. Unit Operations. Bioprocess Eng. Princ. 2013, 11, 445–595. [Google Scholar] [CrossRef]
- McKeen, L.W. Markets and Applications for Films, Containers, and Membranes. Permeabil. Prop. Plast. Elastomers 2012, 4, 59–75. [Google Scholar] [CrossRef]
- Akhondi, E.; Zamani, F.; Tng, K.H.; Leslie, G.; Krantz, W.B.; Fane, A.G.; Chew, J.W. The Performance and Fouling Control of Submerged Hollow Fiber (HF) Systems: A Review. Appl. Sci. 2017, 7, 765. [Google Scholar] [CrossRef]
- Kochkodan, V.; Tsarenko, S.; Potapchenko, N.; Kosinova, V.; Goncharuk, V. Adhesion of microorganisms to polymer membranes: A photobactericidal effect of surface treatment with TiO2. Desalination 2008, 220, 380–385. [Google Scholar] [CrossRef]
- Atkinson, A.J.; Wang, J.; Grzebyk, K.; Zhang, Z.; Jung, D.; Zeng, D.; Pollard, A.; Gold, A.; Coronell, O. Scalable fabrication of anti-biofouling membranes through 2-aminoimidazole incorporation during polyamide casting. J. Membr. Sci. 2019, 579, 151–161. [Google Scholar] [CrossRef]
- Dong, C.; Wang, Z.; Wu, J.; Wang, Y.; Wang, J.; Wang, S. A green strategy to immobilize silver nanoparticles onto reverse osmosis membrane for enhanced anti-biofouling property. Desalination 2017, 401, 32–41. [Google Scholar] [CrossRef]
- Ayyaru, S.; Pandiyan, R.; Ahn, Y.-H. Fabrication and characterization of anti-fouling and non-toxic polyvinylidene fluoride -Sulphonated carbon nanotube ultrafiltration membranes for membrane bioreactors applications. Chem. Eng. Res. Des. 2018, 142, 176–188. [Google Scholar] [CrossRef]
- Matin, A.; Laoui, T.; Falath, W.; Farooque, A.M. Fouling control in reverse osmosis for water desalination & reuse: Current practices & emerging environment-friendly technologies. Sci. Total Environ. 2020, 765, 142721. [Google Scholar] [CrossRef] [PubMed]
- Zunita, M.; Makertihartha, I.G.B.N.; Saputra, F.A.; Syaifi, Y.S.; Wenten, I.G. Metal Oxide based Antibacterial Membrane. IOP Conf. Ser. Mater. Sci. Eng. 2018, 395, 012021. [Google Scholar] [CrossRef]
- Shen, L.; Huang, Z.; Liu, Y.; Li, R.; Xu, Y.; Jakaj, G.; Lin, H. Polymeric Membranes Incorporated With ZnO Nanoparticles for Membrane Fouling Mitigation: A Brief Review. Front. Chem. 2020, 8, 224. [Google Scholar] [CrossRef] [PubMed]
- Jin, T.; Sun, D.; Su, J.; Zhang, H.; Sue, H.-J. Antimicrobial Efficacy of Zinc Oxide Quantum Dots againstListeria monocytogenes, SalmonellaEnteritidis, andEscherichia coliO157:H7. J. Food Sci. 2009, 74, M46–M52. [Google Scholar] [CrossRef] [PubMed]
- Liu, Y.; He, L.; Mustapha, A.; Li, H.; Hu, Z.; Lin, M. Antibacterial activities of zinc oxide nanoparticles against Escherichia coli O157:H7. J. Appl. Microbiol. 2009, 107, 1193–1201. [Google Scholar] [CrossRef]
- Jones, N.; Ray, B.; Ranjit, K.T.; Manna, A.C. Antibacterial activity of ZnO nanoparticle suspensions on a broad spectrum of microorganisms. FEMS Microbiol. Lett. 2008, 279, 71–76. [Google Scholar] [CrossRef] [PubMed]
- Zhang, L.L.; Chen, B.; Xie, L.L.; Li, Z.F. Study on the Antimicrobial Properties of ZnO Suspension against Gram-Positive and Gram-Negative Bacteria Strains. Adv. Mater. Res. 2011, 393-395, 1488–1491. [Google Scholar] [CrossRef]
- Hong, J.; He, Y. Effects of nano sized zinc oxide on the performance of PVDF microfiltration membranes. Desalination 2012, 302, 71–79. [Google Scholar] [CrossRef]
- Zhao, L.; Wu, C.; Liu, Z.; Zhang, Q.; Lu, X. Highly porous PVDF hollow fiber membranes for VMD application by applying a simultaneous co-extrusion spinning process. J. Membr. Sci. 2016, 505, 82–91. [Google Scholar] [CrossRef]
- Kim, J.H.; Joshi, M.K.; Lee, J.; Park, C.H.; Kim, C.S. Polydopamine-assisted immobilization of hierarchical zinc oxide nanostructures on electrospun nanofibrous membrane for photocatalysis and antimicrobial activity. J. Colloid Interface Sci. 2018, 513, 566–574. [Google Scholar] [CrossRef]
- Dzinun, H.; Othman, M.H.D.; Ismail, A.F.; Puteh, M.H.; Rahman, M.A.; Jaafar, J. Morphological study of co-extruded dual-layer hollow fiber membranes incorporated with different TiO2 loadings. J. Membr. Sci. 2015, 479, 123–131. [Google Scholar] [CrossRef]
- Kamaludin, R.; Puad, A.S.M.; Othman, M.H.D.; Kadir, S.H.S.A.; Harun, Z. Incorporation of N-doped TiO2 into dual layer hollow fiber (DLHF) membrane for visible light-driven photocatalytic removal of reactive black 5. Polym. Test. 2019, 78, 105939. [Google Scholar] [CrossRef]
- Shi, H.; Liu, F.; Xue, L. Fabrication and characterization of antibacterial PVDF hollow fibre membrane by doping Ag-loaded zeolites. J. Membr. Sci. 2013, 437, 205–215. [Google Scholar] [CrossRef]
- Roshani, R.; Ardeshiri, F.; Peyravi, M.; Jahanshahi, M. Highly permeable PVDF membrane with PS/ZnO nanocomposite incorporated for distillation process. RSC Adv. 2018, 8, 23499–23515. [Google Scholar] [CrossRef]
- Dzinun, H.; Othman, M.H.D.; Ismail, A.F.; Puteh, M.H.; Rahman, M.A.; Jaafar, J. Fabrication of Dual Layer Hollow Fibre Membranes for Photocatalytic Degradation of Organic Pollutants. Int. J. Chem. Eng. Appl. 2015, 6, 289–292. [Google Scholar] [CrossRef][Green Version]
- Ilyas, S.U.; Pendyala, R.; Marneni, N. Dispersion behaviour and agglomeration effects of zinc oxide nanoparticles in ethanol–water mixtures. Mater. Res. Innov. 2014, 18, S6-179. [Google Scholar] [CrossRef]
- Teow, Y.H.; Ahmad, A.L.; Lim, J.K.; Ooi, B.S. Preparation and characterization of PVDF/TiO2 mixed matrix membrane via in situ colloidal precipitation method. Desalination 2012, 295, 61–69. [Google Scholar] [CrossRef]
- Myint, M.T.Z.; Kumar, N.S.; Hornyak, G.L.; Dutta, J. Hydrophobic/hydrophilic switching on zinc oxide micro-textured surface. Appl. Surf. Sci. 2013, 264, 344–348. [Google Scholar] [CrossRef]
- Bojarska, M.; Nowak, B.; Skowroński, J.; Piątkiewicz, W.; Gradoń, L. Growth of ZnO nanowires on polypropylene membrane surface—Characterization and reactivity. Appl. Surf. Sci. 2017, 391, 457–467. [Google Scholar] [CrossRef]
- Yu, H.-Y.; He, X.-C.; Liu, L.-Q.; Gu, J.-S.; Wei, X.-W. Surface modification of polypropylene microporous membrane to improve its antifouling characteristics in an SMBR: N2 plasma treatment. Water Res. 2007, 41, 4703–4709. [Google Scholar] [CrossRef]
- Efome, J.E.; Baghbanzadeh, M.; Rana, D.; Matsuura, T.; Lan, C.Q. Effects of superhydrophobic SiO2 nanoparticles on the performance of PVDF flat sheet membranes for vacuum membrane distillation. Desalination 2015, 373, 47–57. [Google Scholar] [CrossRef]
- Hir, Z.A.M.; Abdullah, A.H.; Zainal, Z.; Lim, H.N. Photoactive Hybrid Film Photocatalyst of Polyethersulfone-ZnO for the Degradation of Methyl Orange Dye: Kinetic Study and Operational Parameters. Catalysts 2017, 7, 313. [Google Scholar] [CrossRef]
- Shirazi, M.M.A.; Kargari, A.; Tabatabaei, M.; Ismail, A.F.; Matsuura, T. Assessment of atomic force microscopy for characterization of PTFE membranes for membrane distillation (MD) process. Desalination Water Treat. 2014, 54, 295–304. [Google Scholar] [CrossRef]
- Ardeshiri, F.; Salehi, S.; Peyravi, M.; Jahanshahi, M.; Amiri, A.; Rad, A.S. PVDF membrane assisted by modified hydrophobic ZnO nanoparticle for membrane distillation. Asia-Pac. J. Chem. Eng. 2018, 13, e2196. [Google Scholar] [CrossRef]
- Nasrollahi, N.; Aber, S.; Vatanpour, V.; Mahmoodi, N.M. The effect of amine functionalization of CuO and ZnO nanoparticles used as additives on the morphology and the permeation properties of polyethersulfone ultrafiltration nanocomposite membranes. Compos. Part B Eng. 2018, 154, 388–409. [Google Scholar] [CrossRef]
- Wei, J.; Qiu, C.; Tang, C.Y.; Wang, R.; Fane, A.G. Synthesis and characterization of flat-sheet thin film composite forward osmosis membranes. J. Membr. Sci. 2011, 372, 292–302. [Google Scholar] [CrossRef]
- Tseng, H.-H.; Zhuang, G.-L.; Su, Y.-C. The effect of blending ratio on the compatibility, morphology, thermal behavior and pure water permeation of asymmetric CAP/PVDF membranes. Desalination 2012, 284, 269–278. [Google Scholar] [CrossRef]
- Xiong, J.; Gong, Y.; Ma, C.; Zuo, X.; He, J. Fabrication and characterization of polyvinylidene fluoride/zinc oxide membranes with antibacterial property. J. Water Supply Res. Technol. 2019, 69, 122–133. [Google Scholar] [CrossRef]
- Liang, S.; Xiao, K.; Mo, Y.; Huang, X. A novel ZnO nanoparticle blended polyvinylidene fluoride membrane for anti-irreversible fouling. J. Membr. Sci. 2012, 394-395, 184–192. [Google Scholar] [CrossRef]
- Sirelkhatim, A.; Mahmud, S.; Seeni, A.; Kaus, N.H.M.; Ann, L.C.; Bakhori, S.K.M.; Hasan, H.; Mohamad, D. Review on Zinc Oxide Nanoparticles: Antibacterial Activity and Toxicity Mechanism. Nano-Micro Lett. 2015, 7, 219–242. [Google Scholar] [CrossRef]
- Xu, Q.; Yang, J.; Dai, J.; Yang, Y.; Chen, X.; Wang, Y. Hydrophilization of porous polypropylene membranes by atomic layer deposition of TiO2 for simultaneously improved permeability and selectivity. J. Membr. Sci. 2013, 448, 215–222. [Google Scholar] [CrossRef]
- Rabiee, H.; Vatanpour, V.; Farahani, M.H.D.A.; Zarrabi, H. Improvement in flux and antifouling properties of PVC ultrafiltration membranes by incorporation of zinc oxide (ZnO) nanoparticles. Sep. Purif. Technol. 2015, 156, 299–310. [Google Scholar] [CrossRef]
- Rosnan, N.; Teow, Y.H.; Mohammad, A.W. The Effect of ZnO Loading for the Enhancement of Psf/ZnO-GO Mixed Matrix Membrane Performance. Sains Malays. 2018, 47, 2035–2045. [Google Scholar] [CrossRef]
- Drioli, E.; Quist-Jensen, C.; Giorno, L. Molecular Weight Cutoff. In Encyclopedia of Membranes; Drioli, E., Giorno, L., Eds.; Springer: Berlin/Heidelberg, Germany, 2016. [Google Scholar] [CrossRef]

| Composition (wt.%) | ZnO/PVDF AHFM | PVDF Hollow Fiber Membrane | ||
|---|---|---|---|---|
| M2.5 | M5.0 | M7.5 | MNeat | |
| ZnO | 2.5 | 5 | 7.5 | - |
| PVDF | 21 | 21 | 21 | 21 |
| DMAc | 76.5 | 74 | 71.5 | 79 |
| Membranes | Outer Diameter (μm) | Inner Diameter (μm) | Thickness (μm) |
|---|---|---|---|
| MNeat | 1750 | 1490 | 260 |
| M2.5 | 1700 | 1410 | 290 |
| M5.0 | 1810 | 1470 | 340 |
| M7.5 | 1780 | 1400 | 380 |
| Membranes | CA (°) | Porosity (%) | Average Pore Size (nm) |
|---|---|---|---|
| MNeat | 79.27° | 52.60 | 72.66 |
| M2.5 | 78.06° | 51.38 | 75.22 |
| M5.0 | 74.61° | 48.90 | 132.72 |
| M7.5 | 70.93° | 44.06 | 161.54 |
Publisher’s Note: MDPI stays neutral with regard to jurisdictional claims in published maps and institutional affiliations. |
© 2022 by the authors. Licensee MDPI, Basel, Switzerland. This article is an open access article distributed under the terms and conditions of the Creative Commons Attribution (CC BY) license (https://creativecommons.org/licenses/by/4.0/).
Share and Cite
Kamaludin, R.; Abdul Majid, L.; Othman, M.H.D.; Mansur, S.; Sheikh Abdul Kadir, S.H.; Wong, K.Y.; Khongnakorn, W.; Puteh, M.H. Polyvinylidene Difluoride (PVDF) Hollow Fiber Membrane Incorporated with Antibacterial and Anti-Fouling by Zinc Oxide for Water and Wastewater Treatment. Membranes 2022, 12, 110. https://doi.org/10.3390/membranes12020110
Kamaludin R, Abdul Majid L, Othman MHD, Mansur S, Sheikh Abdul Kadir SH, Wong KY, Khongnakorn W, Puteh MH. Polyvinylidene Difluoride (PVDF) Hollow Fiber Membrane Incorporated with Antibacterial and Anti-Fouling by Zinc Oxide for Water and Wastewater Treatment. Membranes. 2022; 12(2):110. https://doi.org/10.3390/membranes12020110
Chicago/Turabian StyleKamaludin, Roziana, Lubna Abdul Majid, Mohd Hafiz Dzarfan Othman, Sumarni Mansur, Siti Hamimah Sheikh Abdul Kadir, Keng Yinn Wong, Watsa Khongnakorn, and Mohd Hafiz Puteh. 2022. "Polyvinylidene Difluoride (PVDF) Hollow Fiber Membrane Incorporated with Antibacterial and Anti-Fouling by Zinc Oxide for Water and Wastewater Treatment" Membranes 12, no. 2: 110. https://doi.org/10.3390/membranes12020110
APA StyleKamaludin, R., Abdul Majid, L., Othman, M. H. D., Mansur, S., Sheikh Abdul Kadir, S. H., Wong, K. Y., Khongnakorn, W., & Puteh, M. H. (2022). Polyvinylidene Difluoride (PVDF) Hollow Fiber Membrane Incorporated with Antibacterial and Anti-Fouling by Zinc Oxide for Water and Wastewater Treatment. Membranes, 12(2), 110. https://doi.org/10.3390/membranes12020110

